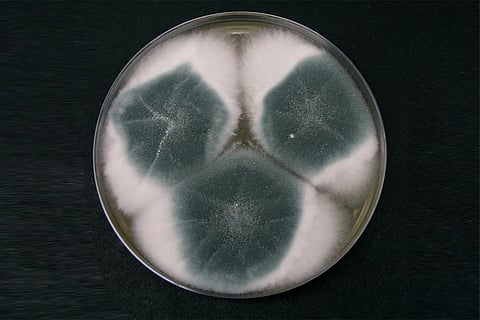

वैश्विक स्तर पर जलवायु में आते बदलावों और बढ़ते तापमान के साथ फंगल डिजीज (फंफूद से होने वाली बीमारियों) का खतरा भी बढ़ रहा है, लेकिन आज तक केवल चार प्रकार की एंटिफंगल दवाएं ही उपलब्ध हैं। ऐसे में एंटी-फंगल रेसिस्टेन्स यानी फफूंद-रोधी प्रतिरोध से निपटने के लिये विश्व स्वास्थ्य संगठन (डब्लूएचओ) ने 19 खतरनाक फफूंदों की सूची तैयार की है जोकि इंसानी स्वास्थ्य के लिए बड़ा खतरा हैं।
डब्लूएचओ द्वारा जारी रिपोर्ट की मानें तो दुनिया भर में जलवायु में आते बदलावों के कारण यह फफूंद अपनी भौगोलिक सीमा में विस्तार कर रहे हैं, जबकि कुछ फंगल डिजीज कोरोना महामारी के दौरान भी फैल गई हैं।
रिपोर्ट के मुताबिक दुनिया भर में जलवायु में आते बदलावों के कारण यह फफूंद अपनी भौगोलिक सीमा में विस्तार कर रहे हैं, जबकि कुछ फंगल डिजीज कोरोना महामारी के दौरान भी फैल गई हैं। इन के बढ़ते खतरे को ध्यान में रखते हुए डब्ल्यूएचओ ने 19 फफूंद रोगजनकों की पहली सूची प्रकाशित की है, जिन्हें विशेषज्ञों ने सार्वजनिक स्वास्थ्य के लिए सबसे बड़े खतरों में शामिल किया है।
इन फफूंद रोगजनकों यानी पैथोजन्स को सूचीबद्ध करने का प्रमुख उद्देश्य इनके बारे में शोध को बढ़ावा देना और फफूंद संक्रमण व बढ़ते फफूंद-रोधी प्रतिरोध से निपटने के उपायों को बेहतर बनाना है। अपनी इस सूची में डब्लूएचओ ने इन 19 रोगजनकों को तीन समूहों अति महत्वपूर्ण, उच्च और मध्यम वर्ग में बांटा है।
गौरतलब है कि विश्व स्वास्थ्य संगठन ने जिन फफूंदों को गंभीर श्रेणी में वर्गीकृत किया है उनमें क्रिप्टोकोकस नियोफॉर्मन्स, कैंडिडा ऑरिस, एस्परगिलस फ्यूमिगेटस और कैंडिडा अल्बिकन्स शामिल हैं।
बीमार और कमजोर इम्युनिटी वाले लोग हैं आसान शिकार
रिपोर्ट के अनुसार इन फंगल डिजीज का खतरा उन लोगों के लिए सबसे ज्यादा है, जो पहले ही स्वास्थ्य समस्याओं से जूझ रहे हैं या फिर जिनकी रोग प्रतिरोधक क्षमता काफी कमजोर है। पता चला है कि कोरोना महामारी ने इस मुद्दे की गम्भीरता को सामने ला दिया था, जब अस्पताल में भर्ती मरीजों में बड़े पैमाने पर आक्रामक फफूंद के कारण संक्रमण के मामलों में वृद्धि देखी गई थी, जिसके गंभीर नतीजे सामने आए थे।
पता चला है कि आक्रामक फफूंद से होने वाले संक्रमण का सबसे ज्यादा खतरा उन लोगों को है जो पहले ही कैंसर, एचआईवी, अंग प्रत्यारोपण, तपेदिक और लम्बे समय से सांस सम्बन्धी बीमारियों की मार झेल रहे हैं।
इस बारे में डब्लूएचओ ने ट्वीट करते हुए जानकारी दी है कि कुछ फंगल पैथोजन अस्पतालों के आसपास छिपना पसंद करते हैं, जिससे वे सबसे कमजोर मरीजों को अपना निशाना बना सकें। यही वजह है कि कोविड-19 महामारी के दौरान अस्पताल में भर्ती रोगियों में आक्रामक फंगल संक्रमण की घटनाओं में नाटकीय रूप से वृद्धि दर्ज की गई थी।
डब्लूएचओ के अनुसार इसके बढ़ते खतरे का अनुमान इसी से लगाया जा सकता है कि दवा प्रतिरोधी जीवाणु संक्रमण पहले ही सीधे तौर पर दुनिया भरे में हर साल होने वाली 12.7 लाख मौतों के लिए जिम्मेवार है, जबकि कहीं न कहीं सालाना होने वाली 49.5 लाख मौतों में इसकी भूमिका होती है।
डब्लूएचओ ने इस बारे में चिंता जताई है कि दुनिया भर में कैंडिडा ओरल और वैजिनल थ्रश जैसे आम संक्रमणों की वजह बनने वाले फफूंदों में उपचार के प्रति प्रतिरोध बढ़ता जा रहा है और इसके चलते संक्रमण के अधिक आक्रामक रूपों के विकसित होने का खतरा भी बढ़ रहा है। कृषि में बढ़ता एंटीफंगल दवाओं का उपयोग भी इसके लिए कहीं न कहीं जिम्मेवार है।
इतना ही नहीं यदि इस बारे में जारी ताजा आंकड़ों पर नजर डालें तो दुनिया भर में फफूंद संबंधी रोगों की संख्या भी लगातार बढ़ रही है। इसके लिए डब्लूएचओ ने वैश्विक तापमान में होती वृद्धि, महामारी के साथ अन्तरराष्ट्रीय यात्रा व व्यापार में होती वृद्धि समेत अन्य कारणों को जिम्मेवार माना है।
हालांकि विडम्बना देखिए कि वैश्विक स्तर पर अब तक केवल चार प्रकार की फफूंद-रोधी दवाएं ही उपलब्ध हैं, जोकि इनके उपचार के लिए एक बड़ी समस्या हैं। ऊपर से समय के साथ फफूंद संक्रमण के मामले आम होते जा रहे हैं और उनमें उपचार के प्रति प्रतिरोधक क्षमता भी विकसित हो रही है, जो इस समस्या को कहीं ज्यादा गंभीर बना रही है।
इस बारे में विश्व स्वास्थ्य संगठन का कहना है कि इससे भी चिंताजनक यह है कि “अधिकांश फफूंद रोगजनकों के मामले में तुरंत और सटीक निदान नहीं मिल पाता और जो दवाएं मौजूद है वो भी व्यापक रूप से उपलब्ध नहीं हैं या फिर वो लोगों की पहुंच से बाहर हैं।“
डब्लूएचओ ने इसके संक्रमण और बढ़ते फफूंद-रोधी प्रतिरोध के बारे में बेहतर समझ विकसित करने के लिए प्रयोगशालाओं और निगरानी क्षमताओं को बेहतर बनाने की सिफारिश की है। संगठन का कहना है कि बढ़ते फफूंद-रोधी प्रतिरोध के लिए कुछ हद तक फफूंद-रोधी दवाओं का होता अनुचित उपयोग भी जिम्मेवार है। ऐसे में इसपर गंभीरता से ध्यान देने की जरूरत है।